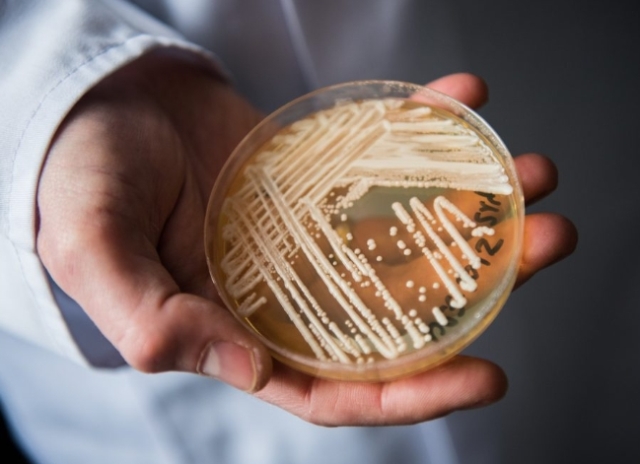

Vorcaro sugere em mensagem que encontro com Lula e ministros foi ‘ótimo’
Mensagens encontradas no celular de Daniel Vorcaro, obtidas pela Polícia Federal (PF), mostram que o ex-banqueiro classificou como “ótimo” o encontro que ele teve em dezembro de 2024 com o presidente Luiz Inácio Lula da Silva e ministros do governo no Palácio do Planalto. O GLOBO teve acesso às trocas de mensagens entre o ex-banqueiro […]
Vorcaro sugere em mensagem que encontro com Lula e ministros foi ‘ótimo’ Read More »